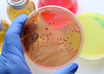

Study finds new approach for designing proteins
IANS | Jul 19, 2017
Ozone pollution tied to cardiovascular health: Study
IANS | Jul 18, 2017
Tweaking brain circuits may alleviate depression
IANS | Jul 18, 2017
Artificial sweeteners may up obesity, heart disease risk
IANS | Jul 17, 2017
Combo therapy better than drug alone against Alzheimer's
ANI | Jul 17, 2017
Are all muscle building supplements are equal?
IANS | Jul 17, 2017
Autistic females face greater difficulty with daily tasks
IANS | Jul 17, 2017
Precision microfluidic device to detect pathogens developed
IANS | Jul 17, 2017
Enzyme to preserve nerve function identified
IANS | Jul 17, 2017
Excess calcium behind dangerous hospital infection
IANS | Jul 15, 2017
Most read this week